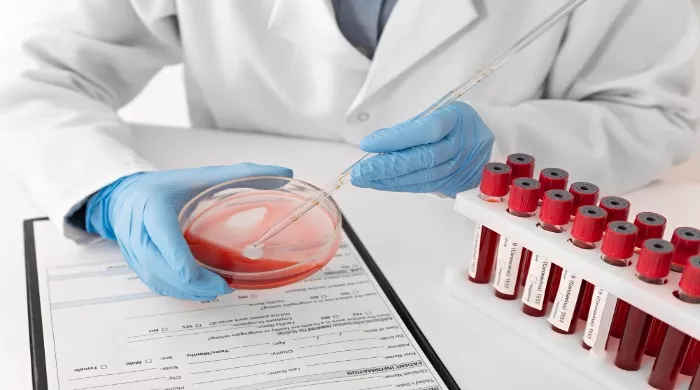

LABORATORIJSKA ANALIZA
Povišen bilirubin u krvi je problem sa kojim se sreće ne tako mali procenat stanovništva.
Bilirubin u krvi može da ukaže na izvesne neregularnosti u organizmu.
Kod nekih ljudi nivo može biti malo povišen, a kod drugih značajno, što ukazuje na neke neregularnosti kod funkcija jetre ili žuči. Za određivanje bilirubina, neophodno je da obavite relevantne laboratorijske analize koje se koriste za ispitivanje hepatobilijarnog sistema.
Bilirubin (vrednosti)
Granice u kojima treba da se nalaze bilirubin diretta i bilirubin totale jesu:
Bilirubin diretta: 0.0 – 6.6 µmol/L
Bilirubin totale: 0.0 – 21.0 µmol/L
Ukoliko vaši nalazi krvne slike pokazuju vrednosti van prikazanih granica, postoji mogućnost da:
– imate problem sa funkcionisanjem jetre
– imate problem sa funkcionisanjem žučne kese
– imate Gilbertov sindrom
– ste hronično umorni i nenaspavani
Povišen bilirubin
Koje korake treba preduzeti ukoliko imate povišene vrednosti bilirubina?Potrebno je obratiti se lakaru i zatražiti izvođenje pregleda ultrazvuka jetre i žučne kese. Ukoliko su vrednosti za bilirubin diretta i bilirubin totale značajno povećani, postoji mogućnost da imate neki ozbiljniji problem sa ova dva organa ili sa jednim od njih. Ukoliko se na ultrazvuku pokaže da su jetra i žučna kesa u redu, onda je moguće posumnjat na postojanje Gilbertovog sindroma.
Gilbertov sindrom (Žilberov sindrom) se manifestuje kao povišen nivo bilirubina u krvi i nivo može prilično da varira. Jedino što možete da preduzmete jeste da se više odmarate i na taj način pomognete vašem telu da lakše metaboliše višak bilirubina. Višak bilirubina se javlja usled nesposobnosti organizma da dovoljno brzo metaboliše bilirubin i da ga prebaci iz nekonjugovanog u konjugovan oblik, u kome on može da se izluči u spoljašnjost putem digestivnog trakta. Potrebno je naglasiti da je ova bolest bezopasna i da se prenosi genima. Dovljno je samo da se više odmarate, da se suzdržavate od konzumiranja alkohola i gaziranih pića, ne izlažete ekstremno teškim fizičkim naporima i pazite da ne dođete u stanje dehidratacije ili teške gladi. Dijagnoza ovog sindroma se utvrđuje tako što se prvo pregledaju jetra i žuč. Ukoliko uzrok povišenog bilirubina nisu ni jetra ni žuč, tada se postavlja dijagnoza Gilbertovog sindroma.
Šta sve podiže bilirubin
Takođe, nivo bilirubina može biti povišen ukoliko ste nenaspavani, umorni, ukoliko ste se izložili nekom većem fizičkom naporu, ukoliko često trenirate i koristite razne suplemente u vidu proteina, ukoliko koristite „metabolički“ zahtevnija sredstava kao što su alkohol i razne droge.
Ako smatrate da se nalazite u ovoj grupi ljudi sa povišenim bilirubinom, prestanite sa lošim navikama, naspavajte se, živite zdravo i nakon dva do tri meseca ponovite nalaz.
Izvor: Stetoskop.info